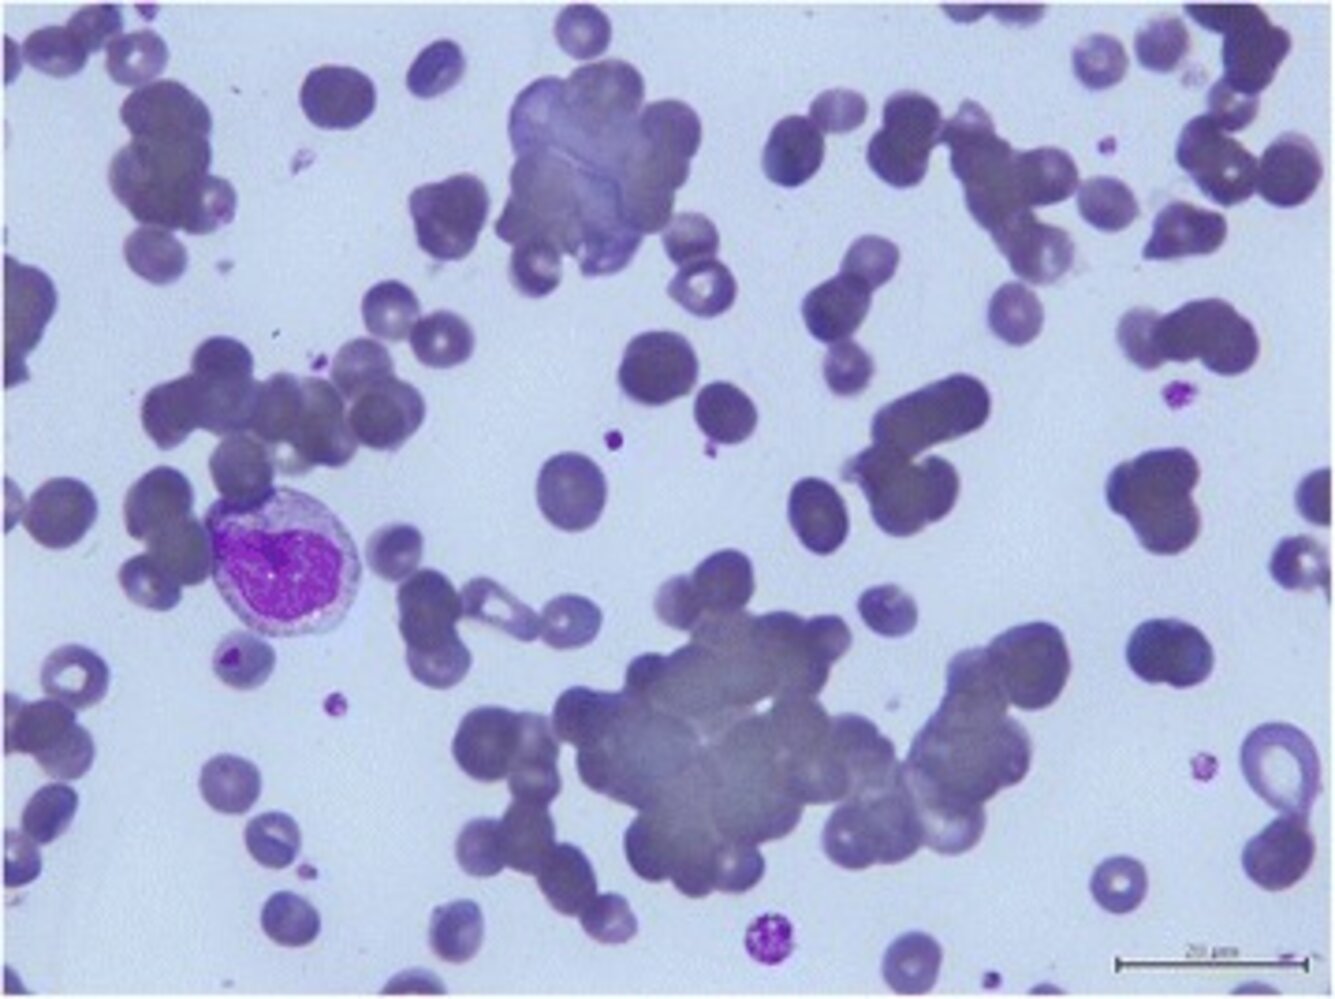
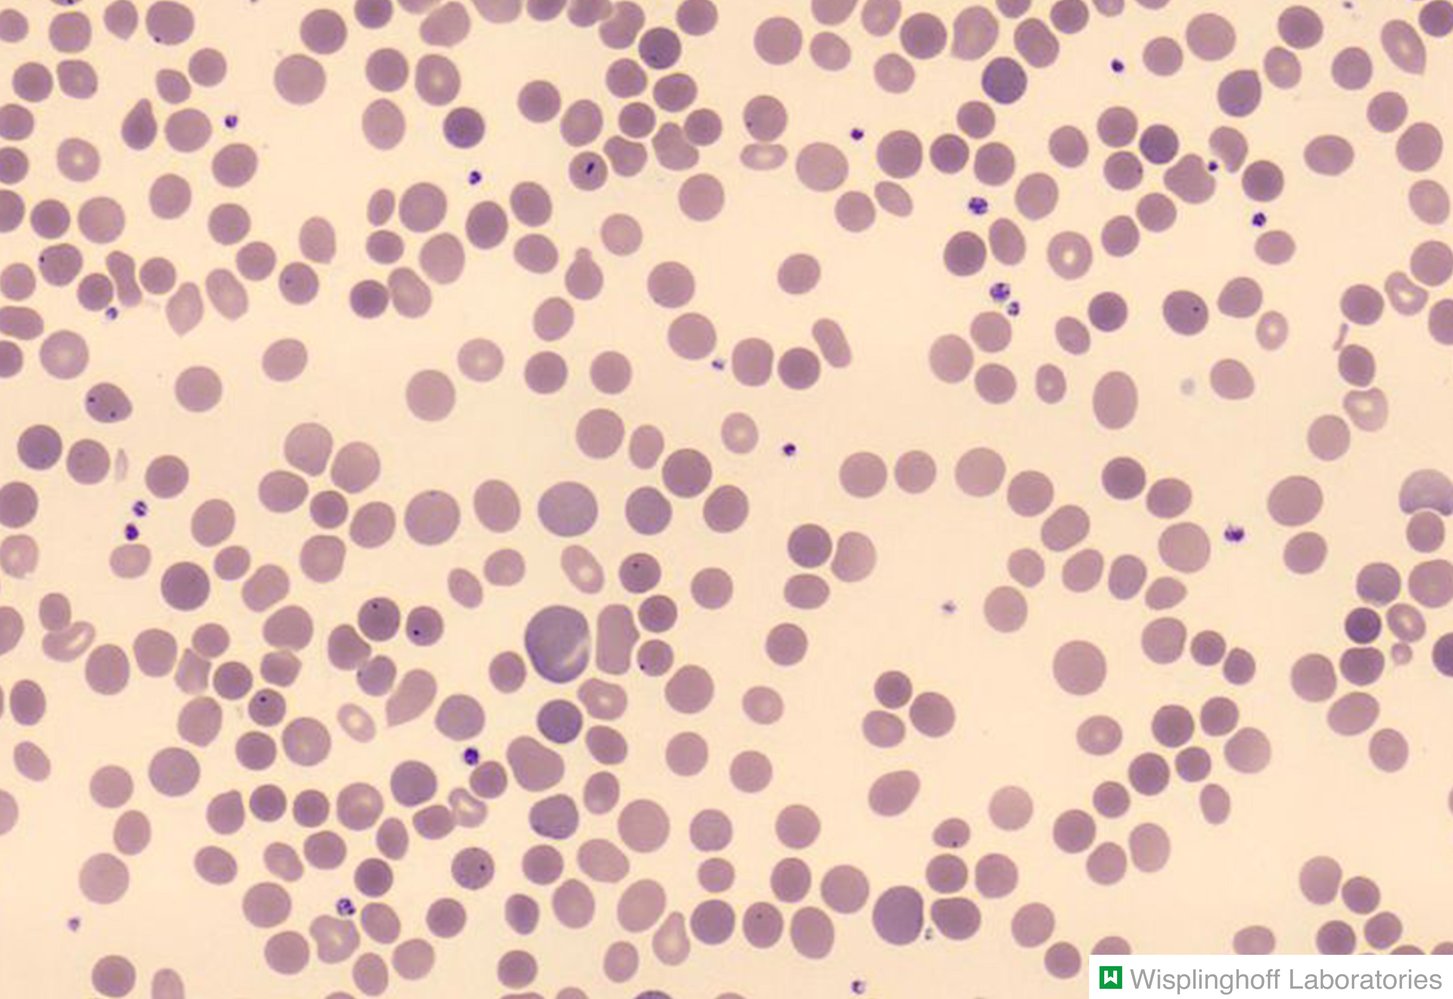

To see contributor disclosures related to this article, hover over this reference: [1]
Physicians may earn CME/MOC credit by searching for an answer to a clinical question on our platform, reading content in this article that addresses that question, and completing an evaluation in which they report the question and the impact of what has been learned on clinical practice.
AMBOSS designates this Internet point-of-care activity for a maximum of 0.5 AMA PRA Category 1 Credit(s)™. Physicians should claim only credit commensurate with the extent of their participation in the activity.
For answers to questions about AMBOSS CME, including how to redeem CME/MOC credit, see "Tips and Links" at the bottom of this article.
Autoimmune hemolytic anemias (AIHAs) are a collection of disorders characterized by the destruction of RBCs through antibody-mediated hemolysis (extravascular and/or intravascular). There are two broad types, categorized by the temperature at which the antigen-antibody reactions maximally occur: cold agglutinin hemolytic anemia (cold AIHA) and warm agglutinin hemolytic anemia (warm AIHA). AIHAs can be either idiopathic or secondary to another disease e.g., infectious, lymphoproliferative, or autoimmune diseases. Cold AIHA and warm AIHA share some characteristics, e.g., they can both present with clinical signs of anemia and laboratory signs of hemolysis, and produce symptomatic anemia severe enough to require blood transfusion. However, their pathophysiology, etiology, epidemiology, clinical and diagnostic features, and targeted treatments all have key differences. Careful clinical and diagnostic evaluation (including direct Coombs testing, antibody titers, and peripheral blood smear) can help distinguish between the types, however, occasionally patients may have a mixed-type AIHA or unusual clinical presentations and laboratory findings. Management depends on the clinical presentation, etiology, and subtype, and is typically performed in consultation with a hematologist. Treatments include stabilization with blood transfusion and temporizing measures (e.g., plasmapheresis, plasma exchange), systemic immunomodulators (e.g., glucocorticoids, rituximab), treatment of underlying conditions, supportive care, and in warm AIHA, splenectomy.
- Both cold AIHA and warm AIHA:
- Are antibody-mediated
- Can present with signs of anemia,
- Can show laboratory signs of hemolysis
- Are acutely treated with blood transfusion for symptomatic anemia
- Patients may occasionally exhibit a mixed-type AIHA or have atypical clinical presentations and initial diagnostic results. [2]
- Hematology consultation is advised if the diagnosis is uncertain.
| Typical distinguishing features of autoimmune hemolytic anemias [2][3] | ||
|---|---|---|
| Cold AIHA | Warm AIHA | |
| Pathophysiology |
|
|
| Etiology |
|
|
| Clinical features |
|
|
| Diagnostics |
|
|
| Acute therapy |
|
|
| Long-term management |
|
|
Typical biochemical findings in hemolysis include ↓ haptoglobin, ↑ LDH concentration, ↑ indirect bilirubin concentration, peripheral blood smear abnormalities (e.g., ↑ reticulocytes, schistocytes, spherocytes, polychromasia), and urinalysis abnormalities (e.g., hemoglobinuria, hemosiderinuria, and urobilinogen).
Background [4][5][6]
-
Definitions: Cold agglutinin hemolytic anemia (cold AIHA) refers to a group of autoimmune disorders characterized by hemolysis that is caused by the binding of cold-sensitive autoantibodies to RBCs [5][7]
- Cold agglutinin disease (CAD): a primary (idiopathic) form of cold AIHA in which hemolysis is mediated by monoclonal cold-sensitive IgM autoantibodies produced by a low-grade clonal B-cell lymphoproliferative disorder of the bone marrow
- Cold agglutinin syndrome (CAS): a rare form of cold AIHA in which cold-sensitive autoantibody-mediated hemolysis occurs secondary to another condition (e.g., infection, lymphoma)
-
Epidemiology [8]
- Cold AIHAs comprise ∼ 10–25% of all AIHAs. [2][7]
- Most common in individuals > 50 years of age [2][9]
Pathophysiology [5]
-
Cold-sensitive antibodies (cold agglutinins): mostly IgM antibodies cause extravascular hemolysis and acute intravascular hemolysis
- Stable disease: extravascular hemolysis of complement-coated RBCs by the mononuclear phagocyte system
- Acute exacerbations: Intravascular hemolysis can occur, mediated through the complement system, which is activated by IgM antibodies bound to RBCs.
- The antigen-antibody reaction is triggered by low body temperature and/or cold ambient temperatures. [5]
Etiology [5]
- CAD: idiopathic
-
CAS occurs secondary to other diseases, including:
- Mycoplasmapneumoniae or EBVinfection
- Malignancy (e.g., non-Hodgkin lymphoma, CLL)
- Waldenstrom macroglobulinemia
Cold weather is MMMMiserable: Cold (IgM) AIHA is seen in Malignancy (CLL), Mycoplasma pneumonia, and Mononucleosis.
Clinical features
- Classically associated with cold exposure
- Can occur as episodes of acute, severe symptoms [2]
- Pallor, fatigue, weakness
- Painful cyanosis of the extremities (acrocyanosis)
- Livedo reticularis
- Raynaud phenomenon
- Skin ulcerations
Diagnostics [5][7][10]
- Indications for testing: typical cold-induced symptoms (e.g., acrocyanosis, livedo reticularis) or unexplained anemia
- Initial investigations: CBC, reticulocyte count, hemolysis workup, DAT, and cold agglutinin titer
-
Additional investigations are indicated to identify secondary causes (i.e., to confirm CAS), for example:
- Bone marrow biopsy and flow cytometry of bone marrow aspirate
- Serum protein electrophoresis
- Workup for infectious diseases or malignancy, e.g., imaging, microbiology
- See also “Antibody-mediated hemolysis.”
-
Diagnostics of cold AIHA can be established in patients with all of the following:
- Evidence of hemolytic anemia
-
Direct coombs test (DAT): Indicates that the patient's RBCs are coated with autoantibodies and/or complement that are causing hemolysis
- DAT positive for C3d
- May also be weakly positive for IgG
- Cold agglutinin titer≥ 64 at 4°C
-
Other potential diagnostic findings (nonspecific)
- PBS: agglutination of RBCs; spherocytes may be seen
- ↓ C3 and C4 due to complement activation
Spherocytes may be seen in both cold AIHA and warm AIHA. However, abundant spherocytosis is characteristic of warm AIHA.
Management [6][10][11]
Approach
The goal is to reduce cold-induced symptoms, control hemolysis, and improve anemia. Hematology consult is advised.
- Compensated hemolysis and mild or absent circulatory symptoms : close surveillance
- Significant clinical manifestations: Start acute therapy.
- CAD: Consider chronic therapy (systemic immunomodulatory).
- CAS: Treat the underlying condition
- Advise all patients to avoid exposure to the cold.
- Consider folic acid supplementation in all patients.
- Manage disease complications: Venous thromboembolism (VTE) [12]
Spontaneous remission is rare in CAD but is common in CAS secondary to infection (e.g., Mycoplasma) and typically occurs within a few weeks of onset. [5][7]
Acute therapy
- Indications: Severe symptoms of anemia or Hb < 7 g/dL
-
Management
- RBC transfusions as needed
- Consider temporizing measures.
- Plasmapheresis
- Trial of glucocorticoids: e.g., prednisolone (however, the response is often poor)
- Consider VTE prophylaxis in patients with acute exacerbations of hemolysis. [7][11]
Long-term therapy
- Indications: CAD with either symptomatic anemia or significant cold-induced symptoms
-
Treatment: Systemic immunomodulators
- First-line treatment: rituximab (anti-CD20 antibody) [6]
- Combination therapy (i.e., rituximab PLUS bendamustine OR fludarabine) is often recommended in severe disease. [6][11]
Splenectomy is not recommended for cold AIHA. It is not effective as most extravascular hemolysis occurs in the liver.
Background [6][8][13][14]
- Definition: an autoimmune disease characterized by the binding of heat-sensitiveautoantibodies to RBCs, which leads to the phagocytosis and destruction of RBCs in the reticuloendothelial system [14]
-
Epidemiology [15]
- Incidence: 1–3 cases/100,000 individuals
- Can occur at any age
Pathophysiology [16]
- Heat-sensitive antibodies: Mostly polyclonal IgG antibodies; that first bind to multiple RBCantigens, then to Fc receptors on phagocytes
- Binding of the antibodies leads to ↑ extravascular hemolysis mediated by the reticuloendothelial system of the spleen and liver. [16]
- The antigen-antibody reaction is triggered by body temperatures of ≥ 37°C/98.6°F
“Warm weather is Great”: Warm AIHA is IgG mediated.
Etiology
- Mostly idiopathic
-
Secondary causes
- Malignancy (lymphoma, chronic lymphocytic leukemia)
- Autoimmune diseases (e.g., SLE)
- Certain drugs (e.g., rifampin, phenytoin, penicillins, α-methyldopa) [17]
Clinical features
- Symptom onset is typically gradual.
- Signs of anemia (pallor, fatigue, weakness)
- Mild splenomegaly
Diagnostics [11]
-
Initial investigations
- Order CBC, reticulocyte count, hemolysis workup, DAT, and PBS.
- Consider warm AIHA in patients with:
- Laboratory evidence of hemolysis
- DAT positive for IgG ± C3d not attributable to another cause (i.e., a recent transfusion or cold agglutinin)
- PBS: abundant spherocytes
- Difficulty findings crossmatch-compatible blood units for transfusion
- Additional investigations: to rule out secondary causes (see “Antibody-mediated hemolysis.”)
Consider warm AIHA in patients with severe anemia for whom the blood bank is unable to find crossmatch-compatible blood units.
Management [6][11][15]
Approach
The goal is to control hemolysis and improve anemia. Early specialist consultation is advised (e.g., hematology, intensive care).
- Manage severe disease acutely.
- Address potential secondary causes (see “Etiology”). [18]
- Hold any potentially causative medications.
- Identify and manage underlying conditions.
- Consider the need for chronic systemic immunomodulators.
- Observation without immunosuppressive interventions may be appropriate for patients with mild asymptomatic anemia.
- Manage disease complications: e.g., VTE
- Monitor for relapses and consider repeated therapeutic intervention.
Acute therapy
- Indications: Severe symptoms of anemia or Hb < 6–7 mg/dL
-
Management
- Provide hemodynamic and respiratory support as needed.
- Alert the blood bank early about the need for a transfusion in a patient with warm agglutinin hemolytic anemia. [15]
- Consider an RBC transfusion under specialist guidance. [6][15][19]
- Consider temporizing measures.
- Early treatment with high-doseglucocorticoids (e.g., methylprednisolone)
- Rescue therapy with IVIG or plasma exchange
- Consider VTE prophylaxis in patients with acute exacerbations of hemolysis. [11]
Do not delay a potentially life-saving blood transfusion in unstable patients with severe anemia, even if crossmatched blood is unavailable. Use type-specific uncrossmatched blood in close consultation with the blood bank. [15]
Long-term therapy
- Indications: Consider in most patients to reduce autoantibody production.
-
Treatment: typically involves systemic immunomodulators
- First-line: high-doseglucocorticoids
- Second-line: rituximab
- Third-line: steroid-sparingimmunosuppressants or splenectomy
References: [6][8][13][14]